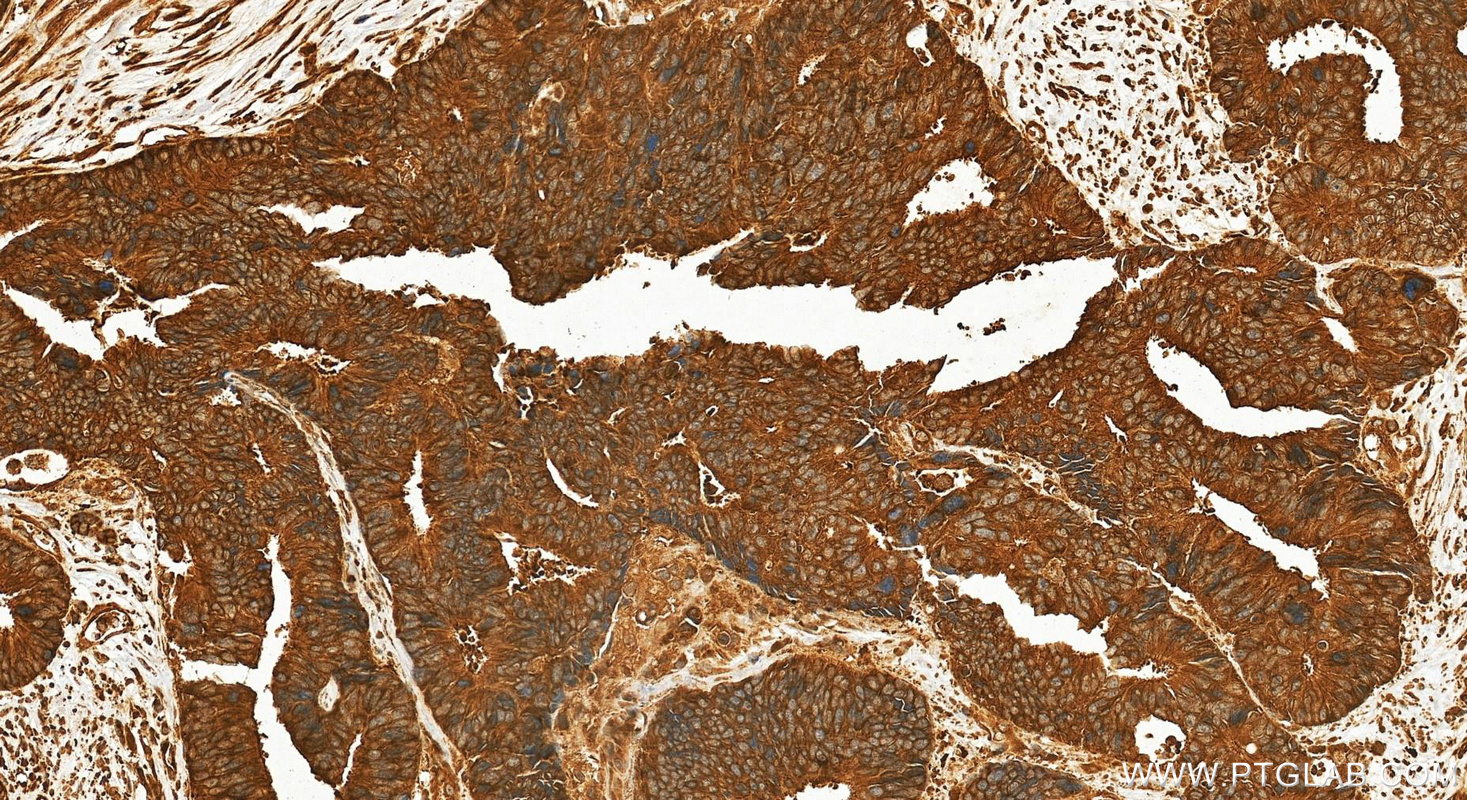
Immunohistochemistry (IHC) staining of human colon cancer tissue using CYP1B1 Polyclonal antibody (18505-1-AP)

Tested Applications
| Positive WB detected in | SKOV-3 cells, MCF-7 cells, PC-3 cells |
| Positive IHC detected in | human colon cancer tissue Note: suggested antigen retrieval with TE buffer pH 9.0; (*) Alternatively, antigen retrieval may be performed with citrate buffer pH 6.0 |
Recommended dilution
| Application | Dilution |
|---|---|
| Western Blot (WB) | WB : 1:500-1:2000 |
| Immunohistochemistry (IHC) | IHC : 1:50-1:500 |
| It is recommended that this reagent should be titrated in each testing system to obtain optimal results. | |
| Sample-dependent, Check data in validation data gallery. | |
Published Applications
| KD/KO | See 1 publications below |
| WB | See 20 publications below |
| IHC | See 4 publications below |
| IF | See 5 publications below |
Product Information
18505-1-AP targets CYP1B1 in WB, IHC, IF, ELISA applications and shows reactivity with human, mouse, rat samples.
| Tested Reactivity | human, mouse, rat |
| Cited Reactivity | human, mouse, rat, monkey |
| Host / Isotype | Rabbit / IgG |
| Class | Polyclonal |
| Type | Antibody |
| Immunogen |
CatNo: Ag13357 Product name: Recombinant human CYP1B1 protein Source: e coli.-derived, PGEX-4T Tag: GST Domain: 1-259 aa of BC012049 Sequence: MGTSLSPNDPWPLNPLSIQQTTLLLLLSVLATVHVGQRLLRQRRRQLRSAPPGPFAWPLIGNAAAVGQAAHLSFARLARRYGDVFQIRLGSCPIVVLNGERAIHQALVQQGSAFADRPAFASFRVVSGGRSMAFGHYSEHWKVQRRAAHSMMRNFFTRQPRSRQVLEGHVLSEARELVALLVRGSADGAFLDPRPLTVVAVANVMSAVCFGCRYSHDDPEFRELLSHNEEFGRTVGAGSLVDVMPWLQYFPNPVRTVFR Predict reactive species |
| Full Name | cytochrome P450, family 1, subfamily B, polypeptide 1 |
| Calculated Molecular Weight | 61 kDa |
| Observed Molecular Weight | 52 kDa |
| GenBank Accession Number | BC012049 |
| Gene Symbol | CYP1B1 |
| Gene ID (NCBI) | 1545 |
| RRID | AB_2878548 |
| Conjugate | Unconjugated |
| Form | Liquid |
| Purification Method | Antigen affinity purification |
| UNIPROT ID | Q16678 |
| Storage Buffer | PBS with 0.02% sodium azide and 50% glycerol, pH 7.3. |
| Storage Conditions | Store at -20°C. Stable for one year after shipment. Aliquoting is unnecessary for -20oC storage. 20ul sizes contain 0.1% BSA. |
Background Information
Cytochrome P450 CYP1B1 is a recently cloned dioxin-inducible form of the cytochrome P450 family of xenobiotic metabolizing enzymes. CYP1B1 was found to be expressed at a high frequency in a wide range of human cancers of different histogenetic types, including cancers of the breast, colon, lung, esophagus, skin, lymph node, brain, and testis. There was no detectable immunostaining for CYP1B1 in normal tissues.(PMID:9230218). CYP1B1 is a 60 kDa protein that it also can be detected a band of 51 kDa or 57 kDa through the western blot(PMID:9525272; PMID: 9525272).
Protocols
| Product Specific Protocols | |
|---|---|
| IHC protocol for CYP1B1 antibody 18505-1-AP | Download protocol |
| WB protocol for CYP1B1 antibody 18505-1-AP | Download protocol |
| Standard Protocols | |
|---|---|
| Click here to view our Standard Protocols |
Publications
| Species | Application | Title |
|---|---|---|
Cell Death Differ The AKR1C1-CYP1B1-cAMP signaling axis controls tumorigenicity and ferroptosis susceptibility of extrahepatic cholangiocarcinoma | ||
NPJ Regen Med Myeloid cell-associated aromatic amino acid metabolism facilitates CNS myelin regeneration | ||
BMC Med NUPR1 contributes to radiation resistance by maintaining ROS homeostasis via AhR/CYP signal axis in hepatocellular carcinoma | ||
PLoS Pathog Reduced IRF4 expression promotes lytic phenotype in Type 2 EBV-infected B cells. | ||
Front Pharmacol Astilbin Activates the Reactive Oxidative Species/PPARγ Pathway to Suppress Effector CD4+ T Cell Activities via Direct Binding With Cytochrome P450 1B1. | ||
J Transl Med piRNA-14633 promotes cervical cancer cell malignancy in a METTL14-dependent m6A RNA methylation manner. |
Reviews
The reviews below have been submitted by verified Proteintech customers who received an incentive for providing their feedback.
FH Hala (Verified Customer) (11-23-2021) | works very good
|